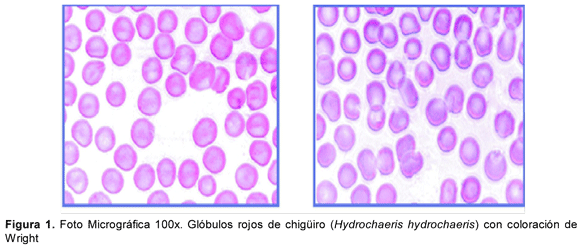

Services on Demand
Journal
Article
Indicators
-
Cited by SciELO -
Access statistics
Related links
-
Cited by Google -
Similars in
SciELO -
Similars in Google
Share
ORINOQUIA
On-line version ISSN 0121-3709
Orinoquia vol.14 suppl.1 Meta Dec. 2010
Artículo Original /Original Article
ESTUDIO DEL PERFIL HEMÁTICO Y METABÓLICO DE CHIGÜIROS (Hydrochaeris hydrochaeris) (LINNAEUS, 1766) EN CONFINAMIENTO
Haematic and metabolic study of chiguiros (Hydrochaeris hydrochaeris)in captivity
José R. Corredor-Matus1, José A. Rodríguez-Pulido2
1 Médico Veterinario Zootecnista, MSc, Profesor asistente Escuela de Ciencias Animales, Universidad de los Llanos, Villavicencio, Meta, Colombia-Grupo de investigación sistemas de producción en especies silvestres GISPES, jcorredormatus@gmail.com
2 Biologo, Msc, Esp., Profesor Asistente, Facultad de Ciencias básicas, Universidad de los Llanos, Villavicencio, Meta, Colombia-Grupo investigación en genetica y reproducción. GIRGA
RESUMEN
El chigüiro (Hydrochaeris hydrochaeris), es considerada actualmente una especie promisoria para la explotación zootécnica, razón por la cual es necesario realizar trabajos que contribuyan a aumentar y fortalecer el conocimiento de la especie en diferentes modelos de explotación ex situ, necesarios para conformar modelos de interrelación animal-medio ambiente-producción. Este estudio esta dirigido a determinar valores de referencia de biometría hemática, química sanguínea, perfil mineral y enzimático, en los chigüiros (Hydrochaeris hydrochaeris), sometidos a cautiverio. Se corrieron muestras a 21 animales de diferentes edades, localizados en tres sitios distintos. Los valores eritrocitícos y leucocitarios fueron obtenidos mediante métodos clásicos de laboratorio. Se utilizo un analizador de Química sanguínea RA-50 para la determinación de proteínas plasmáticas totales, albúmina, creatinina, colesterol, triglicéridos, urea, ácido úrico, bilirrubina directa y total, alanina aminotransferasa (ALT), aspartato amino transferasa (AST), gamma glutamil transferasa (GGT), creatinin fosfoquinasa (CK) y análisis de electrolitos calcio, fósforo, sodio, potasio y cloro. La determinación de glucosa se realizó mediante un glucómetro portátil. Los resultados mostraron, que de acuerdo al estado del desarrollo biológico se encontraron diferencias significativas (p ≤ 0.05) para valores de proteínas plasmáticas totales, recuento de glóbulos blancos, creatinina, AST y BUN. Según el sitio de confinamiento las diferencias fueron significativas (p ≤ 0.05) para volumen corpuscular medio (V.M.C) entre sitio uno y dos. Para V.M.C, BUN, acido úrico, AST y potasio, al comparar medias entre sitio uno y tres. Para calcio al comparar medias entre sitio tres y dos. Se concluye que las células predominantes en el recuento diferencial fueron los neutrófilos que presentan características pseudoeosinofilicas, por lo que algunos autores los han clasificado como eosinófilos, seguido por los linfocitos. Se encontraron diferencias significativas entre algunos parámetros analizados de acuerdo al sitio de muestreo y al estado de desarrollo. Se encontró similitud con parámetros de hematología básica reportados para mamíferos roedores, como valores cercanos en el hematocrito a los del Cotiara (Myoprocta sp), la hemoglobina similar al Ñeque (Dasyprocta sp), Cuy (Cricetus sp), Paca (Cricetus sp) y Cutia (Dassyprocta agouti), V.M.C. cercano al de Cutia y Cuy, la concentración media de hemoglobina corpuscular (C.M.H.C) fue próximo al Hámster (Cricetus sp) y Cuy y cercano al recuento de eosinófilos en el Hámster.
Palabras Clave: Capibara, electrolitos, hematología, restricción química, roedor.
ABSTRACT
Chiguiro (Hydrochaeris hydrochaeris), is a wild specie considered very important to animal products in captivity conditions. It is the reason to carry out studies to increase and become stronger the knowledge of it, in different stages of development in ex situ conditions. This is necessary to build models that include the interrelation between animal-environment-production. The goal of this study is to determine values of reference about hematology biometric, blood chemistry, enzymatic and mineral profiles in chigüiro hydrochaeris hydrochaeris, in captivity conditions. For this purpose 21 animals, of different ages and placed in three different locations, were blooding. Red and white blood cells values were obtain according with traditional methods of laboratory. The blood chemistry was processed by the blood chemistry device RA-50, that reported values of total serum proteins, albumin, creatinin, cholesterol, triglycerides, Bun, uric acid, direct and total bilirubin, alanine aminotransferase (ALT), aspartate amino transferase (AST), gamma glutamil transferase (GGT), creatine phosphokinase (CK), and electrolytes analysis such as Na+, K+, Cl, Ca+2, PO-2. Glucose determination was made by portable glucometro. Results show that according with physiological development stage of animals, significant differences (p ≤ 0.05) were found to total serum proteins, white cells count, creatinin, AST and BUN. According with place of captivity, significant differences (p ≤ 0.05) were found to mean corpuscular volume (MCV), between site one and two; MCV, BUN, uric acid, AST y K+, between site one and three; Ca+ between site three and two; The predominant cells in the differential white cells count were the neutrophiles, which presented characteristics pseudoeosinophils, reason which some authors have classified these cells like eosinophiles; The second place of white cells count, were to lymphocytes. Some parameters of chiguiro's hematology were similar to others mammals rodent, for example: hematocrit values, with species like cotiara (Myoprocta sp), hemoglobin, like Ñeque (Dasyprocta sp), Cuy (Cricetus sp), Paca (Cricetus sp) and Cutia (Dassyprocta agouti), MCV close to Cuy (Cricetus sp) and Cutia (Dassyprocta agouti), mean hemoglobin concentration corpuscular (MHCC), close to Hámster (Cricetus sp) and Cuy (Cricetus sp). Eosinophiles count were close to Hámster (Cricetus sp).
Key words: Capibara, chemical restriction, electrolytes, Hematology, rodent.
INTRODUCCIÓN
El chigüiro (Hydrochaeris hydrochaeris) es el roedor más grande del mundo, adulto mide 1.5 metros de longitud y pesa entre 40 y 70 kg (León 1974), habita zonas bajas inundables (0-1.000 m) desde el canal de Panamá hasta el Norte de Argentina (Azcarate 1980, Emmons 1997). Se encuentran muy adaptados a la vida semiacuática debido a que sus ojos, orejas y orificios nasales se encuentran ubicados proporcionalmente muy arriba en la cabeza, lo que le permite esconderse en el agua dejando afuera únicamente el extremo superior (Ojasti1973).En Colombia existen dos subespecies:.
La subespecie Hydrochaeris isthmius (Torres & Sanabria 1976, Trebbau 1980) distribuida en la Costa Atlántica y Choco y la Hydrochaeris hydrochaeris se distribuye en los llanos Orientales, Caquetá, Putumayo y Amazonas.
El Hydrochaeris hydrochaeris es especie promisoria para su explotación zootécnica por ser herbívoro, tener alta tasa de reproducción, rápido crecimiento, tolerancia a altas densidades y manejo fácil, lo que permitiría trabajar en su conservación y aprovechamiento económico, utilizando estrategias como la implementación de zoocriaderos, que ofrezcan alternativas de producción sostenible (Quintam et al. 1994). Estas características de la especie y su potencial, ponen de presente la necesidad de realizar trabajos de investigación que contribuyan a aumentar y fortalecer el conocimiento de Hydrochaeris hydrochaeris en diferentes modelos de explotación ex situ, tales como la estandarización de valores de referencia en parámetros fisiológicos, necesarios para conformar bases de modelos bioclimáticos de interrelación del animal, medio ambiente y producción.
A pesar del potencial de la especie, en la Orinoquia colombiana son escasos los estudios fisiológicos que sirvan de base para el diagnostico clínico, de gran utilidad para la comprensión de la especie en sistemas de producción. Diferentes autores han logrado establecer valores de referencia para algunos roedores (Fowler 1986, González 1995, Sousa 1996, Mangrich 1996, Martínez 1997). Estudios hematológicos del Hydrochaeris hydrochaeris, se conocen los trabajos de Etzel 1931 y Hawkey & Dennet 1989, en morfología de eritrocitos; Colveé 1976, Jara y Sánchez 1998, Madella 2006, en valores de hematocrito y colesterol; González-Jiménez y Escobar 1975, Arouca et al. 2000, en recuento de eritrocitos; Arouca et al. 2000, Garavito 2000, Jara y Sánchez 1998, 2Madella 2006 y ISIS 2008, en valor de hemoglobina, determinación de índices eritrociticos y recuento de leucocitos; Kaneko 1997, ISIS 2008, en determinación del recuento plaquetario; González 1995 y Arouca et al. 2000, en determinación de proteínas totales y albuminas; Colveé 1976, Rubiano 2000, ISIS 2008, reportaron datos sobre concentración de glucosa sanguínea, acido úrico y triglicéridos; González-Jiménez y Escobar 1975, Jara y Sánchez 1998, ISIS 2008 reportan concentraciones de creatinina, bilirrubina, nitrógeno ureico sanguíneo y enzimas como AST, ALT CGT, CK; los reportes de electrolitos como Na, K, Cl, Ca y P, han sido hechos por Colveé 1976, Jara y Sánchez 1998, ISIS 2008.
Este estudio esta dirigido a realizar un aporte al conocimiento de todos los parámetros hemáticos, química sanguínea, perfiles enzimáticos y de minerales en chigüiros ex situ, en su conjunto, evaluando si el estado de desarrollo biológico y las características de los tres diferentes modelos de confinamiento podrían ser significativas en los resultados obtenidos.
MATERIALES Y MÉTODOS
El trabajo se realizó en el Municipio de Villavicencio, ubicado una altura de 420 m.s.n.m., temperatura promedio de 28 °C, precipitación anual de 4050 mm, humedad relativa del 75 %. Se utilizo un total de 21 chigüiros (Hydrochaeris hydrochaeris) así: Animales subadultos (n=10) 6 machos de 4.3 kilos y 4 hembras de 4.25. Animales adultos (n=11) 9 hembras de 39.2 kilos y 3 machos de 40 kilos. Estos animales estaban localizados en tres sitios: Bioparque los Ocarros (n=11), Hacienda San Carlos (n=4) y Finca Villa del Prado (n=6) en el Municipio de Villavicencio Meta mantenidos bajo un régimen de cautiverio. La alimentación consistía en Forrajes como Kingrass y Cayeno; concentrado (conejina), maíz; yuca, zanahoria, plátano, lechuga, acelga, arracacha y diversas frutas de cosecha. Para poder afirmar cuales individuos pertenecían a la categoría de adultos y cuales a subadultos, se estableció para este trabajo, que los individuos con un peso corporal menor a 25 Kg debían ser considerados subadultos y adultos los individuos que pesaban 25 Kg o más, por no encontrarse registros de EDB en animales en cautiverio. Se incluyeron en el estudio únicamente animales que no presentaban signos clínicos de enfermedad (descargas nasales, postración, ataxia, caquexia, emaciación, tos, entre otras).
La toma de muestras siempre se realizo entre las 0600 y las 1200 h. La restricción física de los animales se realizo mediante una malla (nasa) utilizando un protocolo de manejo modificado aprobado por la corporación ambiental CORMACARENA. La técnica de inmovilización fue la misma para todos los animales con el objeto de uniformizar el efecto sobre los análisis de sangre (Seal et al. 1972, Kock et al. 1987, Meyer & Harvey 1998). Para la obtención de sueros, los animales fueron muestreados con agujas vacutainer y equipos venocat calibre 18' o 21' basados en el eritrocito del capibara que tiene un diámetro que varia de 8,5 a 9,0 mm (Etzel, 1931; Hawkey & Dennet, 1989, Citado en Arouca, M.E. et al 2000).
El protocolo para la restricción química utilizado en Hydrochaeris cautivos fue la combinación de Atropina 1mg, Xilazina 20 mg y ketamina 50 mg, en dosis de 0.044 mg/kg, 0.5 mg/kg y 3 mg/kg respectivamente modificado de Szabuniewicz et al 1978, citado en González-Jiménez 1995. La mezcla anestésica se administro vía IM. Una vez inmovilizado, se realizaba restricción visual, se tomaban parámetros fisiológicos de frecuencia respiratoria, cardiaca y temperatura corporal. Se realizó el registro del sexo, el peso corporal (Kg) y la morfometría teniendo en cuenta; la longitud total (LT), desde la articulación atlantooccipital hasta la última vértebra caudal; el perímetro torácico y el perímetro abdominal para cada animal.
Se colectaron 15 ml de sangre de la vena cefálica o safena mediante equipo venocat y tubos vacutainer con EDTA para hematología básica y tubos con acelerador de coagulación para química sanguínea y perfiles enzimático y de minerales. Los tubos fueron debidamente rotulados e identificados Inmediatamente fueron recolectadas todas las muestras se refrigeraron a 4° C. Los tubos fueron transportados al Laboratorio clínico de la Universidad de los Llanos para el análisis de hematología básica en donde se utilizaron las siguientes técnicas Para el análisis de hematología básica se utilizaron las siguientes técnicas: determinación de hematocrito mediante la microcentrifugación; hemoglobina por la técnica de Cianometahemoglobina; Recuento total de células rojas y células blancas en cámara de Neubauer. Los cálculos de los índices eritrociticos Volumen corpuscular medio (VCM), hemoglobina corpuscular media (HCM) y concentración media de hemoglobina corpuscular (CMHC), se hicieron conforme al método de Wintrobe. La medición de glucosa fue realizada en sangre completa inmediatamente extraída, por medio de un glucómetro portátil marca OneTouch Ultra de Johnson & Johnson. Los sueros fueron enviados al laboratorio clínico de la Facultad de Medicina Veterinaria y Zootecnia de la Universidad Nacional de Colombia para la determinación de creatinina, colesterol, triglicéridos, urea, ácido úrico y bilirrubina directa y total, el contenido de transaminasas sanguíneas (AST Y ALT) y (GGT), creatinin fosfoquinasa (CK) y el análisis de electrolitos Calcio, fósforo, sodio, potasio y cloro. Los sueros se procesaron mediante un analizador automatizado para química sanguínea de referencia RA-50 utilizando sus respectivos kits SPINREACT
La información fue analizada mediante estadística descriptiva en el programa SPSS 12.0. Posteriormente se compararon las medias con una prueba "t" para las variables independientes, estado de desarrollo biológico teniendo en cuenta adultos, subadultos y sitio de confinamiento. Se estableció como nivel de significancia una p≤0.05.
RESULTADOS
Los eritrocitos del Hydrochaeris hydrochaeris son células de forma circular con un citoplasma basófilo. Poseen un diámetro que varía de 8,5 a 9,0 mm, similar al de un elefante. (Etzel 1931, Arouca et al. 2000). La figura 1, muestra los eritrocitos de la especie.
Los resultados para biometria hematica para cada sitio de muestreo, se presentan en la Tabla 1.

Para esta variable, las diferencias fueron significativas únicamente para volumen corpuscular medio (VCM), mostrando los demás parámetros uniformidad en los resultados. Es importante tener en cuenta el valor relativamente bajo de los eosinófilos. La Tabla 2 muestra los parámetros hemáticos de acuerdo con el grado de desarrollo.

Se encontraron diferencias significativas para el recuento de eritrocitos, con una media mas baja para el caso de los adultos, aunque con una desviación estándar mucho mayor. El recuento de eosinófilos, también mostro diferencias significativas, siendo mayor el resultado en el grupo de los subadultos, que podría ser resultado de cuadros parasitarios.
Con respecto a la química sanguínea, la Tabla 3, detalla los valores encontrados para estas variables, de acuerdo el sitio de confinamiento. Nueve de los diez parámetros analizados, mostraron uniformidad en su comportamiento, con excepción del nitrógeno ureico sanguíneo (BUN), que mostro diferencias significativas, en donde el sitio de confinamiento tres, los valores hallados fueron muy elevados, con respecto a los sitios uno y dos. Podría pensarse que el sitio tres, tuvo condiciones más desfavorables que los otros dos.

Sitio 1. Bioparque los Ocarros, 2- Hacienda San Carlos, 3- Villa del Prado. (Villavicencio: Meta).
De acuerdo con el estado de desarrollo, la Tabla 4 detalla los resultados encontrados para los parámetros de química sanguínea. Se observa que los valores de proteínas plasmáticas totales, creatinina y BUN, mostraron diferencias estadísticamente significativas, en donde el grupo poblacional de adultos, mostró los mayores registros. Esto podría ser un reflejo, de la mayor actividad muscular, correspondiente a una mayor actividad física precaptura, de estos ejemplares.

Los valores de electrolitos y enzimas séricas, de acuerdo con el sitio de muestreo, se detallan en la tabla 5, Se encontraron diferencias significativas en las mediciones de calcio y potasio, en el caso de los primeros, registrándose en el sitio tres, los registros mas bajos, que de nuevo, puede ser reflejo de condiciones mas adversas para estos ejemplares, en su sitio de reclusión.

De acuerdo con el grado de desarrollo, la Tabla 6 muestra los resultados de los valores de electrolitos y enzimas séricas. Como puede apreciarse, se encontraron diferencias significativas en los registros enzimáticos de AST y CK, en donde la población de adultos, mostro las concentraciones mas bajas, especialmente en la CK. La AST es considerada como un marcador de funcionamiento hepático y de lesión de tejidos blandos como los músculos, que para el caso de los subadultos, podrían ser más sensibles a este daño en una captura. Los valores encontrados en los adultos, se acercan más a los reportados para la especie por otros autores (Jaouen 1981; Cohen y Loew 1984; Reis et al, 1996; Jara y Sánchez 1998, ISIS 2002). La CK tiene una consideración similar, lo que podría indicar una condición de estrés mayor en la población subadulta.

DISCUSIÓN
Al utilizar dolores de referencia de parámetros herméticos y séricos de cualquier especie, en especial de las sildestres, se debe considerar que los métodos de captura (físico, químico) y de obtención de muestras, tienen efectos sobre los dalores de estos parámetros (Wesson et al. 1979, Mautz et al. 1980). Igual influencia pueden tener el tiempo de persecución, la temperatura ambiental, el comportamiento del animal, factores que deben tenerse en cuenta al interpretar los resultados.
En los animales capturados mediante restricción química, algunas dariaciones obserdadas en los parámetros sanguíneos pueden ser debidas a la excitación predia a la anestesia más que a los efectos del fármaco. (Chapple et al. 1991). Otros factores que pueden influir en el resultado son: sexo, edad, (Jaoeuen 1981, Chapple et al. 1991), la condición general del animal, el estado de salud y el habitat de los animales (Seal et al. 1972, Seal et al. 1978).
El aumento de estos dalores se atribuye a la contracción esplénica, que proporciona a la masa muscular una gran cantidad de eritrocitos oxigenados que permiten al animal una huida rápida y sostenida durante un largo periodo de tiempo (Wesson et al. 1979), y en parte, a la disminución del dolumen plasmático.
La captura química en cambio, prodoca disminución en el recuento de eritrocitos, del dalor del hematocrito y la concentración de hemoglobina. Esto se debe a un efecto de hemodilución por la expansión del dolumen con líquido extracelular y por el secuestro de eritrocitos en el bazo (Seal et al. 1972, Wesson et al. 1979, Wilson y Pauli 1982). El efecto relajante de la acepromacina, clorpromacina, los barbitúricos y el halotano sobre el bazo, hace que los eritrocitos queden retenidos en este (Seal et al. 1972).
Los recuentos total y diferencial de leucocitos también se den afectados por la respuesta al estrés. La secreción de adrenalina hace aumentar la circulación de sangre y de linfa. Esto hace que los leucocitos retenidos en los dasos capilares (reserda marginal) y en los nodulos linfáticos, pasen a la sangre periférica, causando una leucocitosis con neutrofilia y/o linfocitosis. Su efecto es transitorio y normalmente dura menos de 30 minutos. Por otro lado, la secreción de corticosteroides prodoca leucocitosis, neutrofilia, linfocitopenia y eosinopenia (Wesson et al. 1979).
Los nideles eledados de potasio sérico también se han relacionado con la respuesta al estrés (Kock et al. 1987, Peinado et al. 1993). Sin embargo, al interpretar los nideles de potasio hay que tener en cuenta posibles errores preanalíticos, debido a que la eledada concentración de potasio existente en el interior de los eritrocitos, puede prodocar una falsa hiperpotasemia, si se presenta hemolisis (Wesson et al. 1979). Es importante resaltar estas consideraciones, para interpretar en su justa medida, los resultados que aquí se han presentado.
El Recuento de Glóbulos Rojos fue de 4130.7 µlx103 ± 817.0 en el total de la población muestreada, este dalor es similar a los reportados por Madella (2006) 4500 µlx103y Coldeé (1976) 4670 µlx103, y ligeramente superior al reportado por ISIS (2008) 3490 µlx103, Arouca (2000) 3610 µlx103, y Garadito (2000) 3200 µlx103.
Comparado con otros mamíferos roedores el dato obtenido es inferior a los reportados para el cuy (Cavia porcellus) 5400 µlx103, cutia (Dassyprocta agouti) 5500 µlx103, paca (Agouti paca) 5900 µlx103, cotiara (Myoprocta sp) 6650 µlx103, ñeque (Dassyprocta sp) 7300 µlx103, hámster (Cricetus sp) 7050 µlx103 y rata (Ratus ratus) 8270 µlx103 (Cohem 1984, Proano & Reyes 1991, Mangrich 1996).
El porcentaje de hematocrito obtenido en el total de la población muestreada fue de 42.4 ± 4.27 % presentando proximidad con los datos reportados por Madella (2006) 40.4 %, ISIS (2008) 41.7 % en confinamiento y Jara y Sánchez (1998) 41.5 % en vida silvestre, pero más bajos que los obtenidos por Garavito (2000) de 47 % en confinamiento. Comparado con otros roedores es ligeramente cercano a lo reportado para la cotiara (Myoprocta sp) 41 % y menor al de la cutia (Dassyprocta agouti) 48 % y el ñeque (Dassyprocta sp) 45 %.
De acuerdo con el estado de desarrollo biológicos, los resultados obtenidos en subadultos y adultos fue de 42.32 ± 4.37 % y 42.47 ± 4.38 % respectivamente. Al comparar los resultados entre muestreos se nota un ligero incremento del hematocrito con respecto a la altura de los sitios, así: Bioparque Los Ocarros 41.14 % a 378 m.s.n.m., Hacienda San Carlos 43.6 % a 387 m.s.n.m. y Finca Villa del Prado 44.0 % a 435 m.s.n.m.
Este aumento relativo es proporcional al incremento altitudinal, debido a que el transporte de oxigeno a los pulmones es más difícil a medida que la altura se hace mayor y es necesario tener un mayor hematocrito para compensar este evento. Sin embargo, al realizar la prueba estadística las diferencias encontradas no son significativas, lo que indica que los cambios altitudinales no son estadísticamente importantes para este trabajo.
El valor de hemoglobina obtenido en el total de la población fue 14.0 ± 1.49 mg/dl siendo próximo a lo reportado por Madella (2006) 13.5 mg/dl, ISIS (2008) 14.1 mg/dl, Arouca (2000) 15.0 mg/dl en confinamiento y Jara y Sánchez (1998) 13.8 mg/dl y Colveé (1976) 13,13 mg/dl en vida silvestre, pero ligeramente más bajos que los reportados por Garavito (2000) 6.5 mg/dl en cautiverio. Comparado con otros mamíferos roedores los valores obtenidos son cercanos a los reportados para el ñeque (Dassyprocta sp) 11.4 mg/dl, cuy (Cavia porcellus) 13.4 mg/dl, paca (Agouti paca) 13.5 mg/dl, cotiara (Myoprocta sp) 14.0 mg/dl, cutia (Dassyprocta agouti) 14.5 mg/dl e inferior a lo reportado para la rata (Ratus ratus) 16.0 mg/dl y el hámster (Cricetus sp) 16.8 mg/dl.
El Volumen Corpuscular Medio (V.C.M) obtenido en el total de la población fue de 105.95 ± 20.53 U3 fl cercano a lo reportado por Madella (2006) 90.2 U3 fl y a ISIS (2008) 123.2 U3 fl, pero ligeramente menores a lo reportado por Arouca (2000) 131.9 U3 fl y Garavito (2000) 149 U3 fl y similar a los valores reportados para el cuy (Cavia porcellus) 81 U3 fl y a la cutia (Dassyprocta agouti) 86.5 U3 fl, y superior a los reportados para la rata (Ratus ratus) 40.5 U3 fl, cotiara (Myoprocta sp) 61 U3 fl y paca (Agouti paca) 75 U3 fl.
La Hemoglobina Corpuscular Media (H.C.M) en la totalidad de la población muestreada fue 34.93 ± 6.42 U3 pg próximo a lo reportado por Madella (2006) 30.1 U3pg, ISIS (2008) 40.8 U3pg y Arouca (2000) 41.3 U3pg, ligeramente distante a lo obtenido por Garavito (2000) 49 U3pg, El dato obtenido es similar a los reportados para la cutia (Dassyprocta agouti) 31 U3 pg y cotiara (Myoprocta sp) 36.5 U3 pg, inferior al de la rata (Ratus ratus) 49.8 U3 pg y superior a del cuy (Cavia porcellus) 25 U3 pg y paca (Agouti paca) 24 U3pg.
Los valores obtenidos de Concentración Media de Hemoglobina Corpuscular (C.M.H.C) fue 32.77 ± 3.0 % presentando proximidad con los datos reportados por Madella (2006) 33.3 %, ISIS (2008) 34.2 %, Arouca (2000) 31.3 %, Garavito (2000) 35 % y Jara y Sánchez (1998) 33.38 %.
El Recuento de Glóbulos Blancos fue 8699.3 ± 3045.1 mm3 en el total de la población siendo similar al dato reportado por ISIS (2000) 7582 mm3 y Garavito (2000) 7000 mm3 en confinamiento y a Jara y Sánchez (2000) 6784.86 mm3 y Colveé 8638 mm3 en vida silvestre, pero mayor a lo reportado por Madella (2006) 5300 mm3 y Arouca (2000) 4630 mm3 en vida silvestre.
Comparado con otros mamíferos roedores, los datos son similares a los reportados para el hámster (Cricetus sp) 7600 mm3 y cuy (Cavia porcellus) 9900 mm3, inferiores a los de la rata (Ratus ratus) 14900 mm3 y paca (Agouti paca) 14100 mm3 pero superiores a los reportados para ñeque (Dassyprocta sp) 6600 mm3, cutia (Dassyprocta agouti) 5897 mm3 y cotiara (Myoprocta sp) 5500 mm3.
Los neutrófilos arrojaron un valor medio de 58.50±9.43 % en el total de la población, superior a los valores encontrados por ISIS (2008) 44.9 %; Arouca (2000) 43.1-48.6 %, Colveé (1976) 11.7713.63 % en cautiverio, y se encuentran alejados de los valores obtenidos por Garavito (2000) 1%, en poblaciones en confinamiento para el municipio de Villavicencio, así como a los reportados por Madella (2006)33.6 % y Jara y Sánchez (1998) 25.29 % en vida silvestre.
Al comprar este valor con otros roedores, el dato es inferior al de la cutia (Dassyprocta agouti) 70.5 % y superior al de la paca (Agouti paca) 41.55 % ñeque (Dassyprocta sp) 35 %, cuy (Cavia porcellus) 31 %; hámster (Cricetus sp) 29 %, cotiara (Myoprocta sp) 49 % y rata (Ratus ratus) 14.9 %.
En linfocitos los valores medios encontrados fueron de 35.40±9.77 para el total de la población, superior a los reportados para esta especie por ISIS (2008) 30.45 % e inferiores en comparación a los reportados por Arouca (2000) 48.6-49.5 %, Garavito (2000) 58 % y Colveé (1976) 63.45-63.23 % en chigüiros en confinamiento y de los reportados para esta especie en vida silvestre Madella (2006) 58.9% y Jara y Sánchez (1998) 74.24 %.
El valor obtenido es superior con respecto a especies como la cutia (Dassyprocta agouti) 23 % e inferior a los reportados para paca (Agouti paca) 55 %, ñeque (Dassyprocta sp) 48 %, cuy (Cavia porcellus) 55 %; hámster (Cricetus sp) 73.5 %, cotiara (Myoprocta sp) 48 % y rata (Ratus ratus) 82.2 %.
El valor medio para monocitos fue de 3.88±2.62 para chigüiros en confinamiento en las tres poblaciones en Villavicencio, similares a los reportados por ISIS (2008) 3.6 % y por Arouca (2000) 3.8-4.8 %, pero superior a los reportados por Garavito (2000) 0.7 %, Colveé (1976) 0.91-1.54 % y de los reportados en vida silvestre por Madella (2006) 1.5 %.
En comparación con otros roedores es superior a especies como cutia (Dassyprocta agouti) 1.5 %; cuy (Cavia porcellus) 2.5 %; hámster (Cricetus sp) 2.5 %, cotiara (Myoprocta sp) 0.5 % y rata (Ratus ratus) 2.4 % e inferior al de la paca (Agouti paca) 6 % y el ñeque (Dassyprocta sp) 6 %.
Los valores obtenidos en eosinófilos en las tres poblaciones en confinamiento en Villavicencio -Meta fue en promedio 1.19±1.04 El estudio es inferior a los reportados por ISIS (2008) 7.6, Arouca (2000) 3-3.4 y están muy alejados de los reportados por Garavito (2000) 35 y Colveé 20.23-21.85 para esta especie en cautiverio. En vida silvestre inferiores reportados Madella (2006) 3.5 y superiores a reportados Jara y Sánchez (1998) 0.37.
Comparado con otras especies es similar al hámster (Cricetus sp) 1.1 %, y ligeramente superior al de la rata (Ratus ratus) 0.8 % pero inferior a lo reportado en ñeque (Dassyprocta sp) 8 %, paca (Agouti paca) 3.92 %, cuy (Cavia porcellus) 3.5 %, cutia (Dassyprocta agouti) 2 % y superior a cotiara (Myoprocta sp) 0.5 %.
Los Basófilos arrojaron en el total de la población un valor medio de 0.95±1.05, inferior a lo reportado por ISIS (2008) 13.25 %, pero superior al reporte de Jara y Sánchez 0.1 % y similares a Arouca (2000) 0.4-0.5 %
El valor de trombocitos obtenido en el total de la población fue de 264.17 ± 42.49 x103 siendo similar a reportado por el ISIS (2000) 289 x103y comparado con otros roedores es inferior al de la paca (Agouti paca) 314 x103, el cuy (Cavia porcellus) 565 x103y el hámster (Cricetus sp) 670 x103.
En química sanguínea, los valores medios obtenidos para proteínas plasmáticas totales (PPT) fue de 6.12 ±0.83 similares a los obtenidos en ISIS (2008) 6.3 y Arouca (2000) 6.4-6.5, e inferiores a lo reportado por Colveé (1976) 7.85-7.9.
Al comparar estos valores con los reportados para otros roedores es superior a lo citado para el cuy (Cavia porcellus) 5.4 g/dl y a la cutia (Dassyprocta agouti) 5.8 g/dl y similar al hámster (Cricetus sp.) y al cotiara (Myoprocta sp) 6.3 g/dl.
Para albumina (g/dl) el valor medio para el total de la población es 3.16±0.30 que coinciden a los reportados por ISIS (2008) 3.1 y Colveé (1976) 2.853.1. Al compararlos datos con los de otros roedores es inferior con respecto al cuy (Cavia porcellus) 4.3 g/dl, similar con respecto al ñeque (Dasyprocta sp) 2.85 g/dl y 3.0 g/dl de la paca (Agouti paca).
Los valores de glucosa son superiores con respecto a lo reportado por ISIS (2008) 71.04 mg/dl y Colveé (1976) 51.71-57.55 mg/dl, esta diferencia tan marcada en los reportes puede ser debido a la metodología, los reactivos empleados, el periodo de tiempo trascurrido, el procesamiento de las muestras o debido al tipo de alimentación. Al comparar los valores encontrados con los reportados para otras especies encontramos que es similar al del cuy (Cavia porcellus) 120 mg/dl e inferior al del hámster (Cricetus sp) 219 mg/dl.
Para creatinina los valores reportados coinciden con los de ISIS (2008) 1.59 mg/dl son superiores de los reportados en vida silvestre por Jara y Sánchez (1998) 0.89 mg/dl, comparado con otras especies de mamíferos roedores coincide con la rata (Ratus ratus) y la paca (Agouti paca) 1.4 mg/dl y superiores a lo reportado para el cuy (Cavia porcellus) 0.56 mg/dl.
Los valores medios obtenidos para el BUN son inferiores a los reportados por ISIS (2008) 53.55 mg/ dl, Jara y Sánchez (1998) 18.38 mg/dl y Colveé (1976) 38.87 - 45.91 mg/dl. Comparado con otras especies el valor es inferior a lo reportado para ñeque (Dasyprocta sp) 21.45 mg/dl, cotiara (Myoprocta sp) 42.6 mg/dl, cuy (Cavia porcellus) 19 mg/dl y similar a lo reportado para el Hámster (Cricetus sp) 7 mg/dl y la paca (Agoutipaca) 9 mg/dl.
Para el ácido úrico el valor obtenido es superior al reportado por ISIS (2008) 0.95 mg/dl. Por su parte, el valor medio reportado para colesterol es superior a lo reportado por ISIS (2008) 21.24 mg/dl y próximo al reportado por Colveé (1976) 69.73 - 73.00 mg/dl.
Para bilirrubina total y bilirrubina directa los valores obtenidos se encuentran dentro de los reportados ISIS (2008) 0.3 - 0.2 mg/dl y Jara y Sánchez 0.210.12 mg/dl respectivamente.
Para la alanina aminotransferasa (ALT) el valor obtenido se encuentra cercano al reportado por Jara y Sánchez (1998) 69.9 UI/I, pero superior al reportado por ISIS (2008) 44 UI/I. Los valores para el aspartato amino transferasa (AST) se encuentra próximo a lo reportado por Jara y Sánchez (1998) 63.97 UI/I pero superior a lo reportado por ISIS (2008) 40 UI/I. los valores para glutamil transferasa (GGT) esta próximo al reportado por ISIS (2008) 3 UI/I y la creatin kinasa es menor a la reportada por ISIS (2008) 817 UI/I.
El valor obtenido de calcio es similar al reportado por Jara y Sánchez (1998) 9.16 mg/dl e inferior al reportado por ISIS (2008) 2.83 mg/dl. El fosforo es ligeramente inferior a lo reportado por Jara y Sánchez (1998) 4.97mg/dl, e inferior al ISIS (2008) 2.10 mg/ dl. El valor del sodio es similar al reportado por ISIS (2008) 137 mmol/l, el potasio es inferior a lo reportado por el ISIS (2008) 5.2 mmol/dl y el cloro es próximo al reportado por ISIS (2008) 98 mmol/l pero muy inferior al reportado por Colveé (1976) 301 mmol/l.
Analizados los datos podemos concluir, en primer lugar, que el uso de la ketamina y la xilacina, permitió una sedación rápida para una correcta toma de muestras, evitando los efectos indeseables de la restricción física. Se encontró que los leucocitos predominantes en el recuento diferencial fueron los neutrofilos y los linfocitos, planteando la necesidad de realizar mayores estudios para hacer una correcta identificación de los primeros, debido a que por sus características pseudoeosinofilicas, algunos autores han reportado recuentos diferenciales con un alto porcentaje de éstos. Para efectos de la diferenciación de los leucocitarios, es más efectivo el uso de la coloración Wright, debido a que esta permite realizar una mejor observación de los gránulos citoplasmáticos de los neutrofilos.
Los resultados obtenidos al realizar la prueba t para variables independientes según el sitio de confinamiento presentó diferencias estadísticamente significativas (p < 0.05) en: V.M.C entre el Bioparque Los Ocarros y Hacienda San Carlos: peso, V.M.C., neutrofilos, AST, BUN, ácido úrico y potasio entre el Bioparque Los Ocarros y Finca Villa del Prado; calcio, entre Finca Villa del Prado y Hacienda San Carlos.
Al realizar la prueba t para las variables independientes según el estado de desarrollo biológico, se encontraron diferencias significativas (p < 0.05) entre adultos y subadultos en: peso, PPT, recuento de glóbulos blancos, BUN, creatinina, AST y sodio.
Se estableció similitud con algunos valores de hematología básica reportados para otros mamíferos roedores. Se obtuvieron valores cercanos en el hematocrito a los del cotiara (Myoprocta sp), la hemoglobina es similar a la del ñeque (Dasyprocta sp), cuy (Cricetus sp), paca (Cricetus sp) y Catia (Dassyprocta agouti), el V.M.C. fue cercano al de la cutia (Dassyprocta agouti) y el cuy (Cavia porcellus), la C.M.H.C fue próximo al del hámster (Cricetus sp) y cuy (Cavia porcellus) y cercano al recuento de eosinófilos en el hámster (Cricetus sp).
AGRADECIMIENTOS
Los autores expresan agradecimiento al Instituto de Investigaciones de la Orinoquia Colombiana (IIOC), de la Universidad de los Llanos, entidad que financió la ejecución de este proyecto.
REFERENCIAS
Alho R & J. Cleber. 1986. Criaçao e manejo de capibaras em pequenas propiedades rurais. EMBRAPA. Brasilia, D.F., Brasil. [ Links ]
Archer RK, Jeffcott LB. 1977. Comparative clinical hematology. Austrália: Blackwell Scientific Publications. p 737 [ Links ]
Arouca ME, Miranda LB, Lopes R, Takahira RK, Kohayawa A, Carlini PC, Oba E. Valores hematológicos de capivaras (Hydrochoerus Hydrochaeris) criadas em cativeiro no município de Botucatu, SP. Ciência Rural, Santa Maria. 2000; 30: 813-817. [ Links ]
Azcarate T. Sociobiologia y manejo del capibara (Hydrochoerus hydrochaeris). Donana Acta Vertebrata, 1980; (7): 1-228. [ Links ]
Barret MW, Chalmers GA. Clinicochemical values for adults free-ranging pronghorns. Canadian Journal of Zoology. 1997; 55: 1252-1260. [ Links ]
Chapple RS, English AW, Mulley R.C., Lepherd E.E Hoemotology and serum biochemistry of captive unsedated chital deer (Axisbb) in Australia. Journal of Wildlife Diseases, 1991; 27: 396-406. [ Links ]
Cohem, Loew B., Loew F. 1984. Laboratory animal Medicine. Historical Perspectivas, Academia press, United States of America, p 91-158. [ Links ]
Colveé, P. 1976. Parámetros sanguíneos en chigüiros (H.h.). Resumen en 2do. Seminario sobre chigüiro y babas. CONICIT I.P.A.. Facultad de Agronomía U.C.V. Marocay. Mimeo.p. 116. [ Links ]
Emmons, H.L. 1997. Neotropical Rainforest Mommols. The Unidersity of Chicago, Chicago. [ Links ]
Etzel E. Morfología dos elementos do sangue circulante dos cavídeos sildestres. São Paulo, SP 1931, 79p. Tese (Doutorado em Histologia e Embriologia) - Faculdade de Medicina de São Paulo. [ Links ]
Fowler M. E. 1986. Restraint. Zoo and Wild animal medicine, 2 ed. W.B Saunder Company: Philadelphia, p 38-50. [ Links ]
Garavito, M. 2000. Caracterización hematológica del chiguiro (Hidrochoerus Hydrochaeris), Tesis de Grado, Facultad de Ciencias Agropecuarias y Recursos Naturales, Escuela de Medicina Veterinaria y Zootecnia, UNILLANOS. [ Links ]
González, E., 1995. El capibara (Hydrochoerus hydrochaerus) Estado actual de su producción, Estudio FAO Producción y sanidad animal, Roma, p 145-231. [ Links ]
González-Jiménez, E. Y A. Escobar "Digestivilidad comparada en Chigüires (H.h.), conejos y ovinos, con raciones de diferentes proporciones de forrajes y concentrados" Agro. Trop.1975; 25: 283-290. [ Links ]
Hawkey C. M., Dennet T. B. 1989. Atlas de Hematología Veterinaria Comparada, GRASS Ediciones, Barcelona, p 38. [ Links ]
ISIS. 2008. International Species Information System. © Copyright 2008. All right Reserved. [En línea: http://www.isis.org/CMSHOME/] [ Links ]
Jaouen, M. 1981. Étude hematologique et biochimique diune population de chevreuils ( Capreolus capreolus). Tesis Doctoral. Ecola Nationale Vétérinaire d' Alfort. Cedex Francia. [ Links ]
Jara, L.F & Sánchez J.M Estudio Clinico Patológico y de las células de Kurloff en el Chiguiro (Hydrochaeris hydrochaeris Linnaeus) en vida silvestre. Facultad de Medicina Veterinaria. Bogota, 1998. Universidad de la Salle. [ Links ]
Kaneko J. 1997. Clinica biochemestry of domestic animals. 5th edition. Academic press. p 33-456. [ Links ]
Kock M.D., Clark R.K., Franti C.E Jessup D.A., Wehaussen J.D Effects of capture on Biological parameters in free-ranging bighord sheep (Ovis canadensis). Evaluation of normal, stressed and mortality outcomes and documentation of postcapture survival. Journal of Wildlife Diseases. 1987; 23: 652662. [ Links ]
León C.A. 1974. Zoonimia y distribución geográfica del Chigüiro en Colombia. Trabajo presentado en el primer simposio internacional sobre Chigüiro y Babilla. Santafé de Bogotá, Colombia. 9 p. [ Links ]
Madella A.D. Felisberto E.M., Souza E. C. 2006. Valores hematologicos de capivaras (Hydrochoerus hydrochaeris) rodentia: Hydrochoeridae) de vida livre na regiáo de Campiñas - SP, Ciencia Rural, Universidad Federal de Santa Maria, Brasil v. 36, n. 004. [ Links ]
Mangrich. Avalicao dos valores de hemograma de cutia (Dasycropta agouti). Passeio Publico Curitiba, UFPR, inédito. 1996. [ Links ]
Martínez, P. Establecimiento de algunos valores hematicos de referencia en una población de agouti paca en cautiverio Medellin, Colombia. Tesis de grado, Medicina Veterinaria, UDCA. [ Links ]
Mautz W.W., Seal U.S., Boardman C.B 1980 Blood serum análisis of chemical and physically restrained whithe- thailed deer. Journal of Wildlife Management, 1997; 44: 343-351. [ Links ]
Meyer, D.J., Harvey, J.W. 1998. El Laboratorio en Medicina Veterinaria: interpretación y diagnostico, Segunda Edición, Intermedica, Argentina. [ Links ]
Ojasti J. 1973. Estudio biológico del Chigüiro o capibara. Fondo Nacional de Investigaciones Agropecuaria. Editorial Sucre. Caracas, Venezuela. 275 pp. [ Links ]
Peinado V.I., Fernandez A.A., Viscor G., Palomeque J Haematology of Spanish bies (Capra pyrenaica hyspanica). Restrained by physical or chemical jeans. Veterinary records, 1993; 32: 580-583. [ Links ]
Proano, Reyes C., Reyes M. 1991 Estudio de cría y manejo de la guatasa (Dasycropta sp), comparación de tres dietas. Universidad Central del Ecuador, Facultad de Medicina Veterinaria y Zootecnia, p 92-101. [ Links ]
Quintana, R., S. Monge & A. Malvarez. Feeding habits of capybara (Hydrochaeris hydrochaeris) in afforestation areas of the Lower Delta of the Parana River, Argentina. Mammalia 1994; 58: 569-580. [ Links ]
Rubiano, A. P. 2000. Hematologia y quimica snaguinea comparativa entre especies en cautiverio de Agouti paca y Aguoti taczanowkii. Facultad de Medicina Veterinaria. Bogota. Universidad Nacional de Colombia. [ Links ]
Seal U.S., Verme L.J. Ozoga J.J., EricKson A.W. Effects of immobilization on blood analices of white-tailed deer. Journal Wildlife Management, 1972; 36: 1034-1040. [ Links ]
Seal U.S., Hoskinson R.L. Metabolic indicators of habitat condition and capture stress in proghorns. Journal Wildlife Management, 1978; 42: 753-755. [ Links ]
Sousa, K. A., 1996. "Determinacao de proteinas e fracoes sericas em cutias (Dasyprocta primnolopha) mantidas em cativerio." Departamento de Medicina Veterinaria, Escola superior de agricultura de Mossoro, Inedito. [ Links ] [ Links ]
Trebbau P. Some observation on the capybara (Hydrochaeris hydrochaeris). Zool. Garten N.F. Jena. 1980; 1:40-44. [ Links ]
Wesson J.A., Scalon P.F., Kirpatrick R.L., Mosby H.S. Influence of chemical inmobilization and phisical restraind on packed cell dolume, total protein, glucose and blood urea nitrogen in blood of white-tailed deer. Canadian Journal of Zoology. 1979; 57: 756-767. [ Links ]
Wilson W.D, Pauli J.V. Blood constituents of formed red deer (Cerdus elaphus). Haematological values. New Zeland Veterinary Journal, 1982; 30: 174-176. [ Links ]













